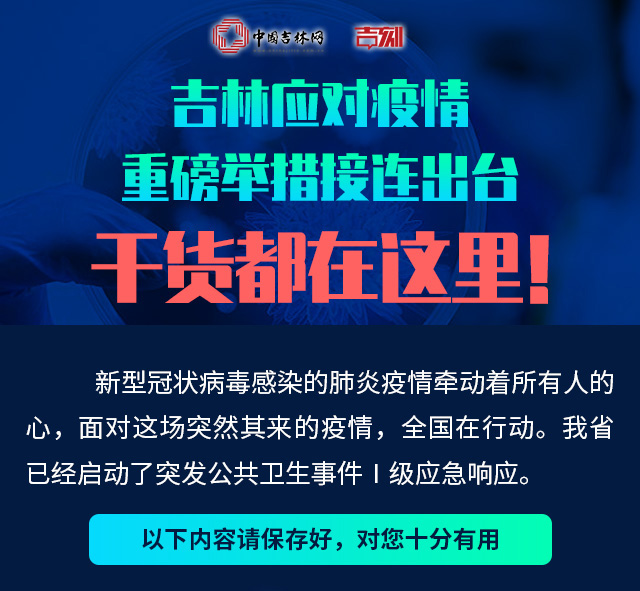

了解吉林疫情最新消息
随着科技的进步,获取信息的渠道日益丰富,我们可以通过官方媒体、政府公告、社交媒体等渠道获取吉林疫情的最新消息,对于初学者和进阶用户来说,了解疫情动态是防控疫情的重要一环。
步骤:
1、访问国家卫生健康委员会官网、吉林省卫生健康委员会官网或当地疫情防控指挥部官网,查看最新疫情通报。
2、关注本地新闻媒体及社交媒体平台,了解本地疫情动态和防控措施。
学习防控技能
防控疫情需要我们掌握一定的知识和技能,包括正确佩戴口罩、洗手、社交距离等。
步骤:
1、观看权威机构发布的防控技能教学视频,如国家卫生健康委员会、央视新闻等。
2、学习正确佩戴口罩的方法,确保口罩覆盖口鼻部,调整金属条以确保贴合度。
3、学会正确洗手的方法,使用肥皂和流动水至少清洗20秒。
4、了解社交距离的重要性,保持至少1米的安全距离。
参与社区防控工作
作为社区的一员,我们都可以为疫情防控做出贡献,无论是初学者还是进阶用户,都可以参与一些力所能及的防控工作。
步骤:
1、报名参加社区防控志愿者,协助社区工作人员进行测温、登记等工作。
2、积极参与社区宣传活动,向邻居宣传防控知识。
3、监督自己及家人遵守防控措施,如居家隔离、减少外出等。
关注疫情变化,调整防控策略
疫情形势可能会随时变化,我们需要根据最新的疫情消息调整我们的防控策略。
步骤:
1、定期检查疫情数据,了解感染人数、治愈人数、死亡人数等关键信息。
2、关注疫情高发地区的变化,了解病毒传播的特点和趋势。
3、根据疫情变化,调整自己的防控策略,如加强个人防护、减少外出等。
保持心理健康,积极应对疫情
面对疫情,保持良好的心理状态同样重要,我们可以通过学习一些心理调适技巧,积极应对疫情带来的压力。
步骤:
1、了解疫情对心理健康的影响,学习如何应对疫情带来的焦虑、恐惧等情绪。
2、通过冥想、瑜伽、阅读等方式缓解压力,保持良好的心理状态。
3、与家人、朋友保持沟通,分享彼此的感受,共同度过难关。
参与疫苗接种工作
疫苗接种是防控疫情的重要手段,我们应该积极参与疫苗接种工作,保护自己和他人的健康。
步骤:
1、关注疫苗接种的最新消息,了解接种对象、接种流程等信息。
2、按照当地政府的安排,预约接种疫苗。
3、接种后遵守相关规定,注意观察身体状况,如有不适及时就医。
面对吉林疫情,我们应该保持关注、学习防控技能、参与社区防控工作、关注疫情变化、保持心理健康并积极参与疫苗接种工作,无论你是初学者还是进阶用户,都可以为疫情防控做出贡献,让我们共同努力,打赢这场疫情防控战役!

京公网安备11000000000001号
京ICP备11000001号
还没有评论,来说两句吧...